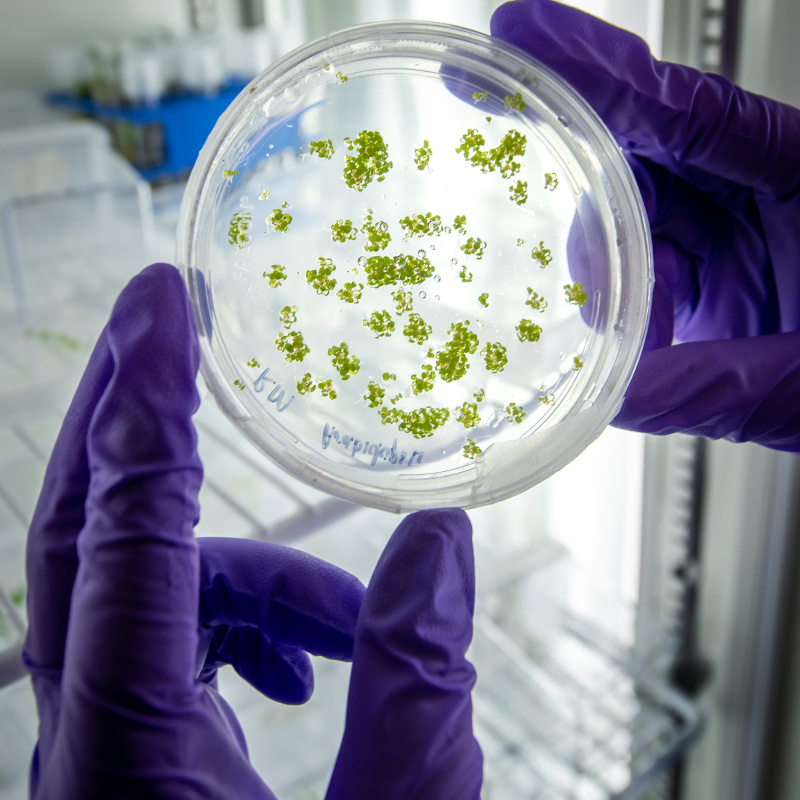
Photo of two gloved hands holding a petri dish up against a light

About
The Department of Energy’s 17 National Laboratories are powerhouse institutions that have led scientific innovation in the United States for more than 70 years. They possess unique instruments and facilities – many of which are found nowhere else in the world – and tackle the critical scientific challenges of our time, from combating climate change to discovering the origins of our universe
Our National Laboratories
Office of Science Laboratories
National Nuclear Security Administration Laboratories
National Lab Highlights
-
 The U.S. Department of Energy (DOE) and DOE’s National Nuclear Security Administration (NNSA) today announced the achievement of fusion ignition at Lawrence Livermore National Laboratory (LLNL)—a major scientific breakthrough decades in the making.
The U.S. Department of Energy (DOE) and DOE’s National Nuclear Security Administration (NNSA) today announced the achievement of fusion ignition at Lawrence Livermore National Laboratory (LLNL)—a major scientific breakthrough decades in the making. -
 Read about some of the ways the National Laboratories have changed and improved the lives of millions of people for more than 75 years.
Read about some of the ways the National Laboratories have changed and improved the lives of millions of people for more than 75 years. -
The Office of Science national scientific user facilities provide researchers with the most advanced tools of modern science.November 24, 2024
The Office of Science national scientific user facilities provide researchers with the most advanced tools of modern science.November 24, 2024

